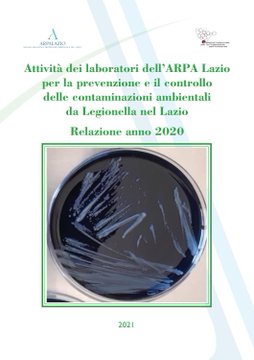
Immagine

in provincia di Latina la più alta percentuale dei controlli non conformi con 52 controlli, 16 non conformi, pari al 30,80%, mentre la media regionale è del 21,90%. Rispetto alla situazione riscontrata nelle altre province del Lazio, l’elevata percentuale di campioni non conformi riferibile alla provincia di Latina è originata dal fatto che tutti gli interventi relativi alla provincia pontina sono stati effettuati in seguito alla segnalazione di casi, a differenza di quanto avvenuto nelle province di Frosinone, Rieti e Viterbo dove i campionamenti sono stati effettuati in prevenzione dalla ASL o dai privati.
La Legionella è uno tra i patogeni più importanti trasmessi attraverso l’acqua ed è responsabile di una grave polmonite interstiziale denominata malattia del legionario, generalmente nota come legionellosi, e di una sindrome lieve simil-influenzale detta febbre di Pontiac. Si tratta di un batterio Gram-negativo aerobio appartenente alla famiglia delle Legionellaceae, rappresentata dal solo genere Legionella, che presenta molte specie distinte in diversi sierogruppi. Legionella pneumophila è la specie più frequentemente coinvolta nei casi diagnosticati ed è costituita da 16 sierogruppi dei quali Legionella pneumophila sierogruppo 1 è causa della maggior parte delle infezioni registrate. Le misure di prevenzione e controllo per contenere la proliferazione di Legionella sono riportate nelle Linee guida per il controllo e la prevenzione della legionellosi – 2015, approvate dalla Conferenza Stato-Regioni nella seduta del 7 maggio 2015 anche in adeguamento al d.lgs. n. 81/2008 che prevede l’obbligo, per il datore di lavoro, di valutare il rischio Legionella sia per i lavoratori che per qualsiasi altra persona che frequenti il luogo di lavoro. Gli specifici obblighi in materia di prevenzione e controllo della legionellosi si possono inquadrare nella più generale valutazione e gestione dell’acqua negli edifici in accordo con il dettato del dm 14 giugno 2017 e secondo le linee guida OMS sulla sicurezza dell’acqua negli edifici. La ricerca di Legionella è tecnicamente complessa e deve avvenire in laboratori specializzati e accreditati. Per questo motivo, e ai fini di una efficace sorveglianza sul territorio nazionale, è stata costituita una rete di Laboratori individuati dalle Regioni, in base ai requisiti necessari per svolgere attività di diagnosi e controllo per Legionella spp., organizzati in livelli gerarchici, con ordine crescente di responsabilità di diagnostica, di attività e di strutture (Laboratorio di base e Laboratorio regionale di riferimento), collegati al Laboratorio nazionale di riferimento, situato presso il Dipartimento di Malattie infettive, parassitarie ed immunomediate dell’Istituto Superiore di Sanità. In caso di cluster i campioni ambientali devono sempre essere analizzati dai laboratori di riferimento regionali. La Regione Lazio ha individuato nell’ARPA Lazio – Agenzia regionale per la protezione ambientale del Lazio – due laboratori di riferimento regionale per le indagini diagnostiche relative al microrganismo Legionella in campioni ambientali nell’ambito del sistema di prevenzione e controllo della Legionellosi (Decreto del Commissario ad Acta 5 dicembre 2019, n. U00495). I due laboratori sono collocati nel Dipartimento prevenzione e laboratorio integrato, precisamente nel Servizio ambiente e salute nella sede territoriale di Roma e nel Servizio per il coordinamento delle attività di laboratorio nella sede territoriale di Latina. Il laboratorio di Roma riceve anche i campioni provenienti dal territorio della provincia di Viterbo mentre il laboratorio di Latina analizza anche campioni prelevati nella provincia di Frosinone. Infine, nell’ambito delle suddette strutture complesse, i campioni della provincia di Rieti sono analizzati dal Laboratorio di base, secondo la definizione riportata nelle Linee guida per il controllo e la prevenzione della legionellosi – 2015, collocato nella sede territoriale di Rieti: l’ARPA Lazio, in questo modo, assicura il servizio di analisi per la ricerca della Legionella in campioni ambientali, con particolare attenzione alla Legionella pneumophila, su tutto il territorio regionale. Oltre alle analisi, l’Agenzia effettua attività tecniche di sopralluogo, ispezione e campionamento intervenendo come supporto tecnico-analitico dei Dipartimenti di prevenzione delle ASL nell’ambito delle loro attività di vigilanza, di controllo a seguito della notifica di casi di polmonite da Legionella e nell’ambito del monitoraggio in ambienti di vita per la valutazione del rischio. I laboratori dell’ARPA Lazio svolgono le attività di sopralluogo, campionamento e analisi anche su richiesta di privati, prevalentemente in strutture ricettive e sanitarie, nell’ambito della loro attività di autocontrollo preventiva o a seguito di interventi di bonifica. L’attività analitica è effettuata in conformità ai requisiti previsti dalla norma UNI CEI EN ISO/IEC 17025:2018 - Requisiti generali per la competenza dei laboratori di prova e di taratura e le prove sono accreditate da ACCREDIA e sono state effettuate secondo il Metodo Unichim 1037:2014 (Ricerca ed enumerazione di Legionella spp. e Legionella pneumophila nelle acque) fino al mese di dicembre 2020, quando è stato sostituito dal metodo UNI EN ISO 11731:2017. La valutazione del metodo e delle prestazioni del laboratorio è stata effettuata con controlli di qualità interni e attraverso la partecipazione a circuiti interlaboratorio di interconfronto. Il limite di sensibilità del metodo è pari a 50 UFC/Litro (20 UFC/l in caso di analisi di 5 litri di acqua). Su altre matrici come tamponi e incrostazioni il risultato analitico è espresso in termini di presenza/assenza. L’impegno dell’ARPA Lazio nella prevenzione e il controllo delle contaminazioni ambientali di Legionella include anche incontri formativi sul campionamento, la partecipazione a tavoli tecnici, nonché la realizzazione di materiale divulgativo come la scheda informativa 12/2019 dal titolo Legionella e Legionellosi: cosa fa l’ARPA LAZIO o la pubblicazione on line del rapporto Attività dei laboratori dell’ARPA Lazio per la prevenzione e il controllo delle contaminazioni ambientali da Legionella nel Lazio – 2019.
tratto da https://www.arpalazio.it/documents/20124/a9e28d5b-20be-62c9-158a-a2ad5cdc935a

Nessun commento:
Posta un commento